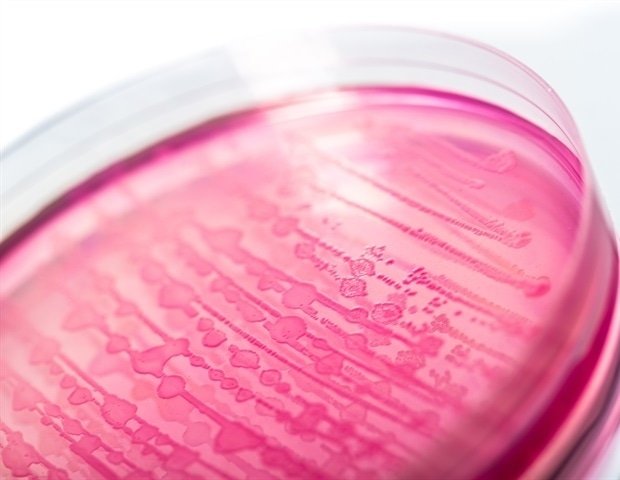

Human cells adapt to ever-changing conditions while maintaining the internal state necessary for survival, but exactly how cells achieve both adaptability and stability remains unclear. Researchers, including those at the University of Tokyo, have used a light-based technique called Raman spectroscopy for the first time to create a snapshot of the entire protein landscape inside E. coli cells in a non-destructive way.
Analysis of the data allowed the team to predict how protein abundance would change under certain conditions. This was previously only possible by extracting the target protein. This allowed us to observe how the abundance of different proteins changes depending on how they relate to basic function or situational adaptability.
All living organisms are made up of cells, and the molecular machinery within cells is essential for survival. Different biomolecules, including RNA, proteins, etc., have specialized roles and perform different functions.
Proteins support the state of life by acquiring and metabolizing nutrients from the external environment, synthesizing new substance molecules for growth and division, and transmitting information depending on the environment. Given its importance, researchers seek to characterize how protein abundance changes under different conditions and how its abundance is regulated within cells.
To determine the abundance of proteins within a cell, a technique known as “proteomics” is often used to create a dataset called a proteome profile. However, standard approaches require protein extraction and quantification, which is destructive and requires many labor-intensive steps. But we found a better way. ”
Yuichi Wakamoto Professor, Department of Basic Science, University of Tokyo
Professor Wakamoto added, “We demonstrated that it is possible to non-destructively estimate a cell’s proteome profile simply by exposing the cell to light and analyzing the so-called Raman spectrum, a type of scattered light from the cell that conveys the molecular profile.”
After discovering this, Wakamoto, along with project researcher Kenichiro Kamei and his team, wanted to understand why it was possible to predict a cell’s protein composition from Raman light measurements and spectra. They found that the abundance ratios of many proteins were globally regulated across different conditions.
A pattern emerged in which the abundance ratio remained constant and contained a large core of proteins that support basic cellular functions. Smaller groups of proteins tend to change more in response to changes in the environment, which helps cells adapt. This hierarchical structure explains how cells can maintain stability while responding flexibly to new conditions, and this study proves that Raman spectroscopy can be a powerful tool for exploring the complex world of cellular machinery.
“The biggest challenge for us was to connect and integrate two separate research fields, optics (in this case Raman spectroscopy) and omics (proteomics), which have developed independently. It took many measurements, data analyzes and mathematical analyzes to be confident that the correspondence between Raman spectra and omics profiles of cells was genuine and had a solid foundation,” Kamei said. “By applying our method, we may be able to predict early changes in cell state associated with disease and the molecular basis driving such changes. It is also important to dig deeper into how this pattern of protein ratios, called stoichiometric conservation, emerges. This is interesting and perhaps important because it is also evident in cell types other than E. coli, including human cells.”
sauce:
Reference magazines:
Kamei, Ki, F., others (2026) Revealing global stoichiometry-conserved structures in cells from Raman spectral patterns. e-life. DOI: 10.7554/eLife.101485.3. https://elifesciences.org/articles/101485.